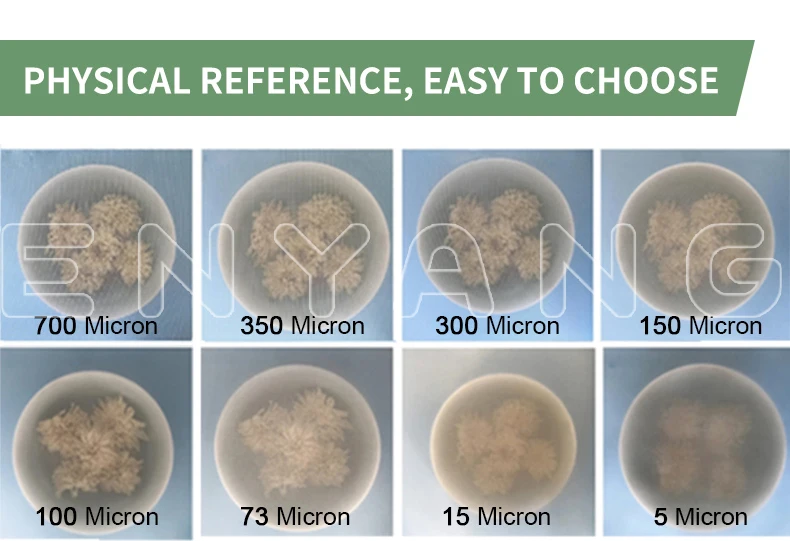

25 micron 90 micron 150 micron nylon polyester mesh filter cloth material roll quarter inch thick
- Category: >>>
- Supplier: Hebei Enyang Import And Export Trading Co. Ltd.
Share on (1601282955579):
Product Overview
Description

Description of the Nylon Filter Mesh
Screen Printing Application
Monofilament nylon mesh features the flexibility and elasticity of nylon PA6 yarn or PA66.
So Nylon Mesh ideal for printing onto curved or rigid surfaces or abrasive substrates.
Features:
Good mechanical and chemical resistance
Excellent emulsion adhesion
Flexible and elastic
Fishing and other industries
The aperture is usually 5 micron, 25 micron, 37 micron, 75 micron, 90 micron, 120 micron, 160 micron,200 micron...... max 2000 micron and others.
Screen Printing Application
Monofilament nylon mesh features the flexibility and elasticity of nylon PA6 yarn or PA66.
So Nylon Mesh ideal for printing onto curved or rigid surfaces or abrasive substrates.
Features:
Good mechanical and chemical resistance
Excellent emulsion adhesion
Flexible and elastic
Fishing and other industries
The aperture is usually 5 micron, 25 micron, 37 micron, 75 micron, 90 micron, 120 micron, 160 micron,200 micron...... max 2000 micron and others.

We Recommend
New Arrivals
New products from manufacturers at wholesale prices


















